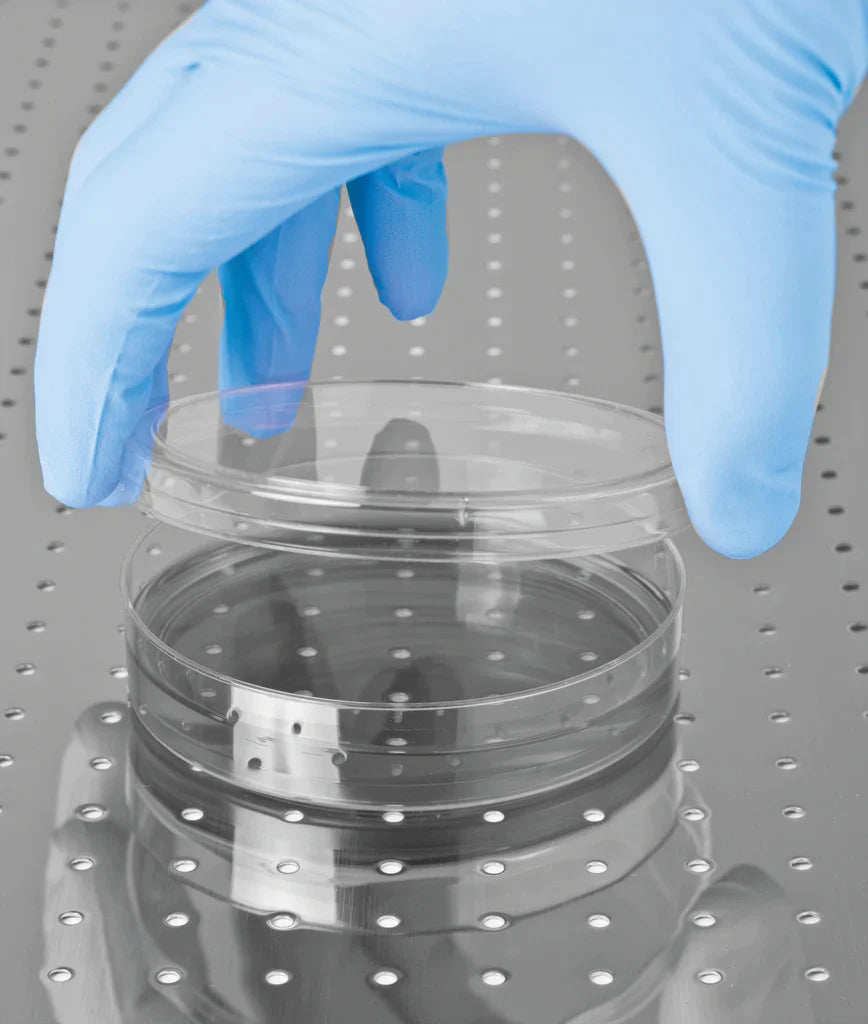

1
/
of
3
speedymeds.co.uk
100 PH HANDSAFE GN83 NITRILE BLUE DISPOSABLE POWDER FREE GLOVES
100 PH HANDSAFE GN83 NITRILE BLUE DISPOSABLE POWDER FREE GLOVES
Regular price
£13.99 GBP
Regular price
Sale price
£13.99 GBP
Unit price
/
per
Tax included.
Couldn't load pickup availability
Manufactured from: Nitrile butadiene
Latex free: reducing the risk of hypersensitivity and allergic reactions
Low in residual chemicals: To reduce the risk of contact dermatitis associated with these chemicals
Flexible material: For improved feel and fit reducing fatigue during extended wear
Strength: Offers better puncture, tear and abrasion resistance than natural rubber or vinyl
Powder free: Reduces the risk of dust contamination
Textured finish: For improved grip
Food Contact: Tested in accordance with European standard EN1186 making it suitable for food contact
Share